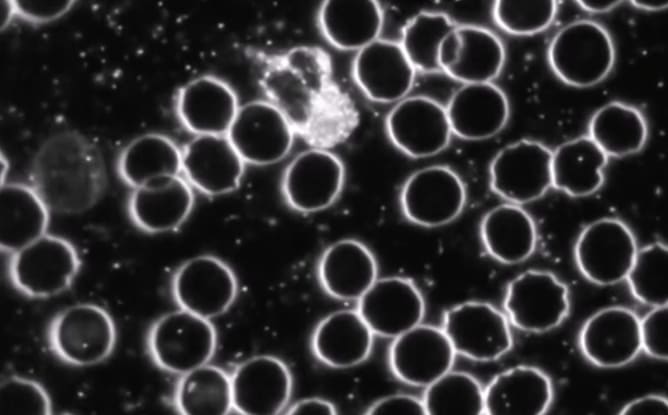

Un outil pour l'analyse du sang vivant
La microscope à fond noir est un outil avec lequel on observe une goutte de sang fraîche (prise au bout du doigt), sans la colorer, grâce à un éclairage particulier. Cela permet de voir les cellules vivantes telles qu’elles sont. Ce type d’examen donne une idée générale de la santé, peut montrer la présence de certains micro-organismes, révéler si les globules rouges ont une forme anormale (ce qui peut indiquer un manque de nutriments), et parfois détecter des signes d’infections bactériennes ou fongiques. C’est un outil génial pour orienter le diagnostic des troubles dont souffrent les patient-es et pour toutes celles et ceux qui souhaitent améliorer leur santé!

Aidez-moi à prendre soin des autres!
Ce projet me tient vraiment à cœur, car ce que j’aime profondément, c’est accompagner les gens pour qu’ils se sentent mieux, dans leur corps comme dans leur tête. L’analyse du sang vivant me donnerait ainsi d’autres lunettes de lecture pour aider mes patient-e-s. Et en plus, c’est assez dingue de voir ses cellules sanguines bouger en direct!
A quoi votre soutien va servir
Votre soutien à cette campagne me permettra d’acquérir un microscope à fond noir et de l’utiliser dans mon cabinet pour mieux accompagner mes patient-e-s en naturopathie.